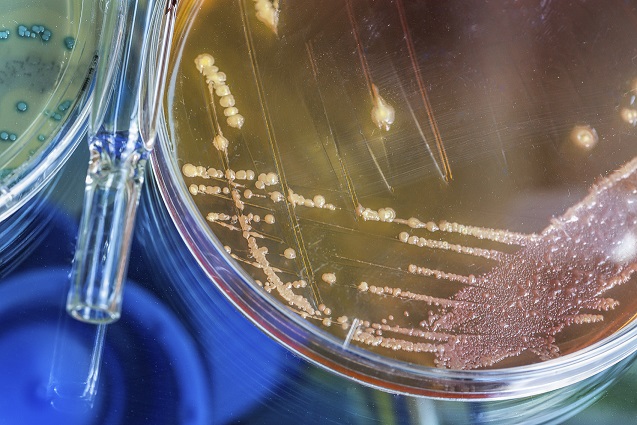

Agrifood Technology is a NATA accredited specialised Microbiological Testing Laboratory - offering complete microbiological services in Food Safety testing.
"Complete Microbiological services in Food Safety Testing"
All testing services carried out adhere to stringent accreditation and quality assurance requirements. Agrifood Technology provides a wide range of microbiological services to assist with your product release requirements, as well as ensuring the safety and hygiene of your production processes.
Download Brochure: Microbiological Fact Sheet
CONTACT US:
Please contact Agrifood Technology for further information on Salmonella testing on: 1800 801 312 OR [email protected]